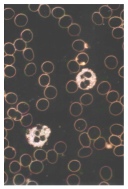

Ingrid Oldenburg





ist eine Anwendung, die durch ein spezielles, temperaturneutrales, rotes Licht mit einer Wellenlänge von 632 nm erfolgt, das durch Leuchtdioden erzeugt wird.
Diese Wellenlänge kann die Zellen stimulieren. Das Energiesystem des Körpers harmonisiert sich und kommt in Fluss. Die Behandlung selbst ist schmerzfrei. Heilungsreaktionen können auftreten.
Stimmt der Energiefluss in Muskeln, Organen und Gefäßen, lösen sich gesundheitliche Störungen auf.
Zellaktivierung ist erwachsen aus zehnjähriger intensiver Forschungs-
Seit Jahrtausenden kennen die Chinesen den feinstofflichen Energiefluss entlang bestimmter Bahnen im Körper, den Energiebahnen oder auch Meridiane genannt.
Jede Energiebahn speist ein Zielgebiet im Körper.
Befindet sich auf diesen Bahnen ein Energiestau (z. B. durch Narben), so fließt nur ein Teil der Energie ins Zielgebiet.
Unsere Muskeln brauchen zum Dehnen Energie. Fehlt diese Energie, verkrampft und verkürzt sich die Muskulatur. Verkürzte Muskeln drücken auf Nerven (z. B. Ischias) oder auf Knorpelscheiben (z. B. Bandscheiben) und verursachen dadurch Schmerzen.
Weil sich in Organen und Gefäßen zahlreiche Muskeln befinden, gilt für sie das Gleiche. Sie werden in ihrer Funktion eingeschränkt.
Durch Zellaktivierung werden diese Energiestaus gelöst.
Fließt die Energie, ist der Mensch gesund.
Dunkelfeldmikroskopie macht die Wirkung der Zellaktivierung sichtbar!
Zellaktivierung ist hilfreich um:
medizinische Anwendungen zu unterstützen
die Selbstheilungskräfte zu aktivieren
übersäuertes Gewebe zu normalisieren
Muskelverspannung aufzulösen
die Vitalität und Leistungsfähigkeit zu steigern
Energiestaus in den Energiebahnen (Meridianen) aufzulösen
das Energieniveau anzuheben
emotionale Muster aufzulösen
den Energiefluss zum Organ wieder herzustellen
als vorbeugende Massnahme zur Gesunderhaltung

Blut unter dem Dunkelfeldmikroskop
Rote Blutkörperchen freischwimmend
Geldrollenbildung
rote Blutkörperchen
stark verschlackt

